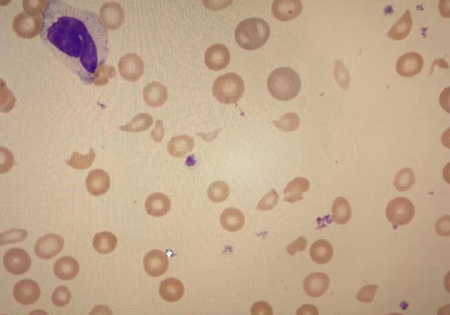

快速反应!重症医学科成功救治罕见病危重产妇
“产妇病情危重,紧急求援!”北京积水潭医院回龙观院区作为昌平区高危孕产妇救治中心,11月2日上午接到求助信息。情况紧急,医务部立即组织专家小组待命,由产科郑秀丽主任医师、重症医学科王郝主任医师及肾内科杨洁副主任医师组成的医疗小组,第一时间前往产妇所在的医院进行会诊。
患者琪琪(化名),33岁,本次停经后47天突发腹部剧烈疼痛,10月25日因异位妊娠、失血性休克收入外院手术治疗。术中发现盆腔大量积血,约1600ml,手术顺利完成,闯过了第一关,琪琪和家人都松了一口气。但在术后第5天,患者开始出现发热,白细胞升高,贫血,血小板明显下降。该院考虑为感染,积极抗感染治疗后,患者病情还在持续加重,肌酐和D-二聚体急速上升,出现下肢静脉血栓,急性肾功能衰竭并转入重症病房。此时,外院已经竭尽全力,多次全院会诊,但琪琪的病情还在加重。11月2日,琪琪的血小板已经低到了非常危险的程度,随即该院发出求援信息!
积水潭医院专家组到达后,仔细了解患者病史,对病程进行抽丝剥茧的分析,很快形成了共识。在琪琪的化验结果里可以看到乳酸脱氢酶、间接胆红素明显升高,溶血的表现很明显,结合急性肾功能衰竭、血小板减少,血栓性微血管病(TMA)诊断比较明确,考虑患者怀孕和大出血的过程,非典型溶血性尿毒症综合征(aHUS)可能性非常大。这是一种罕见的急性危重性疾病,死亡比例高,即便生存下来,患者也有很大概率发展为终末期肾病,需终身透析治疗。可以想象,对于一个33岁的年轻母亲和她的家庭来说,这将是不可想象的打击。
面对这种情况,进一步明确诊断很重要,但及时救治患者更为紧迫。积水潭医院医疗小组决定立即将患者火速收入回龙观院区重症医学科,紧急协调好床位,进行血浆置换。血浆置换需要专用的器材,专业的护理人员及大量的新鲜血浆。输血科紧急调配血浆,给予了充分的支持。重症医学科医护人员奋战到凌晨1点,终于完成了患者的第一次血浆置换。
血浆置换
值得庆幸的是,第二天患者的血色素及血小板得到了明显的改善,乳酸脱氢酶及D-二聚体也呈下降趋势。之后,重症医学科进一步完善了相关检查,送检的血涂片显示>5%的破碎红细胞以及Coombs试验阴性等化验结果进一步明确,患者极有可能发生了非典型溶血性尿毒症综合征(aHUS)。
在输血科的大力支持下,重症医学科为患者完成了连续5天的血浆置换。目前患者的一般情况越来越好,血色素稳定,血小板已正常,肌酐逐渐下降。经过将近一周的积极治疗,11月9日琪琪顺利转出重症病房。
血涂片找破碎红细胞>5%

重症医学科王郝主任医师查房

血常规提示血小板逐渐恢复正常
此次罕见病危重产妇的成功救治,再一次展现了积水潭医院多学科快速反应救治危重孕产妇的团队力量。在未来的日子里,重症医学科将继续全力以赴,为辖区高危孕产妇的安全保驾护航。

患者恢复良好,即将出院
非典型溶血性尿毒症综合征aHUS
非典型溶血性尿毒症综合征(aHUS)是一种非常严重且罕见的疾病,常见于儿童,也可发生于成人,有研究报道成人发病率约为0.2/10万,儿童发病率约为0.33/10万,儿童期罹患aHUS男女没有差异,成人期患者女性多于男性。aHUS是血栓性微血管病(TMA)的一种类型,以微血管病性溶血性贫血、血小板减少和肾脏损害为特征,具有较高的病死率和不良预后。aHUS主要影响肾脏,也有可能导致多器官系统功能障碍,具有不可预测的过程,可能是轻度到重度。即使经过积极的治疗,在某些情况下,可能会出现永久性损伤,尤其是肾脏。目前没有可以证明aHUS的直接测试,临床医生需要根据患者的症状、病史及血、尿、补体及基因等多方面化验检查,在进行初步诊断的同时,尽早开始治疗。目前aHUS的有效治疗方式主要有血浆置换和补体抑制药(如依库珠单抗)。
文丨重症医学科 李智敏
图丨重症医学科 徐晓、王雨薇
编辑丨靳晓方 于淼


